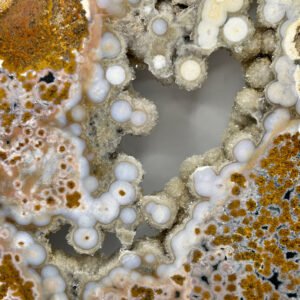
8th Vein Ocean Jasper Slab

Shop
Showing 13–24 of 1505 results
-
Bracelets
6mm Bead Bracelets- Various
£3.00 – £10.00Price range: £3.00 through £10.00 This product has multiple variants. The options may be chosen on the product page -
Carvings
8th Vein Ocean Jasper Slab
£708.00Original price was: £708.00.£637.00Current price is: £637.00. -
Spheres
8th Vein Ocean Jasper Sphere
£564.00Original price was: £564.00.£506.00Current price is: £506.00. -
Pendants
925 Sterling Silver Gold Plated Pendants- mixed
£35.00 This product has multiple variants. The options may be chosen on the product page